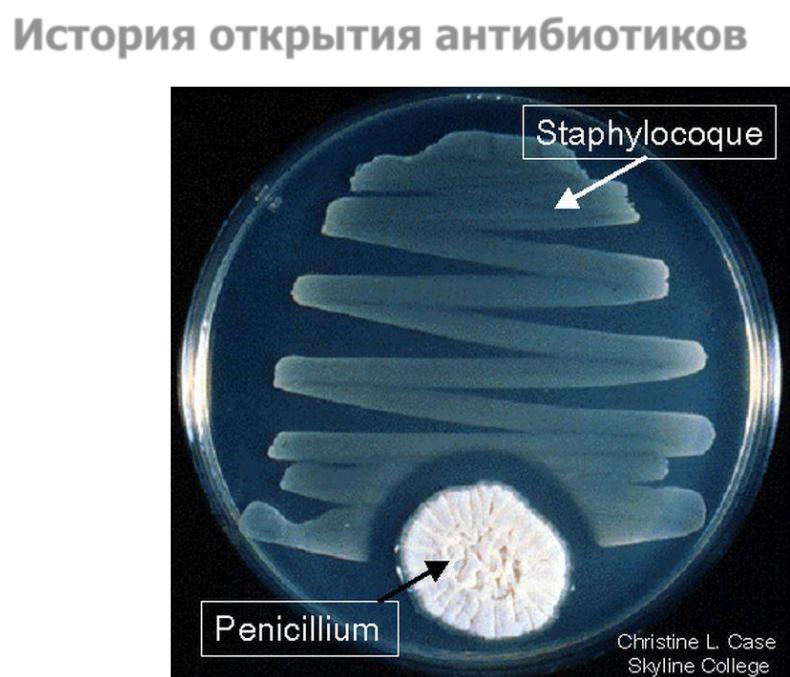

Материал: 02. Антибиотикорезистентность

История открытия антибиотиков
шотландский бактериолог Александр Флеминг (1881-1955)
История открытия антибиотиков

История открытия антибиотиков
Статуя Флеминга стоит возле главной арены для корриды в Мадриде, Плаза де Торос де Лас Вентас

История открытия антибиотиков
1942 г.
получение пенициллина- хрусталина из Penicillium
crustosum
Зинаида
Виссарионовна
Ермольева
Под руководством главы всесоюзного института экспериментальной медицины – З.В. Ермольевой
из плесени, собранной со стен бомбоубежища (Сталинская премия, 1943 год) был получен пенициллин в СССР.
В 1941 году СССР запросил у союзников образец лекарства. Однако ответа не последовало. Тогда
советские ученые разработали собственный штамм пенициллина. Профессор З.В. Ермолаева вместе со своей сотрудницей Т.М. Балезиной выделили и подвергли изучению свыше 90 штаммов плесневых грибков. В 1943 году
началось его промышленное производство
антибиотика. |
9 |
|
1898-1974

История открытия антибиотиков
За всю историю человечества не было другого лекарства, которое спасло бы столько человеческих жизней. "Для победы во Второй Мировой войне пенициллин сделал больше, чем 25 дивизий!"
Именно такие слова прозвучали при вручении
Флемнгу, Чейну и Флори
Нобелевской премии по биологии и медицине в 1945 г.